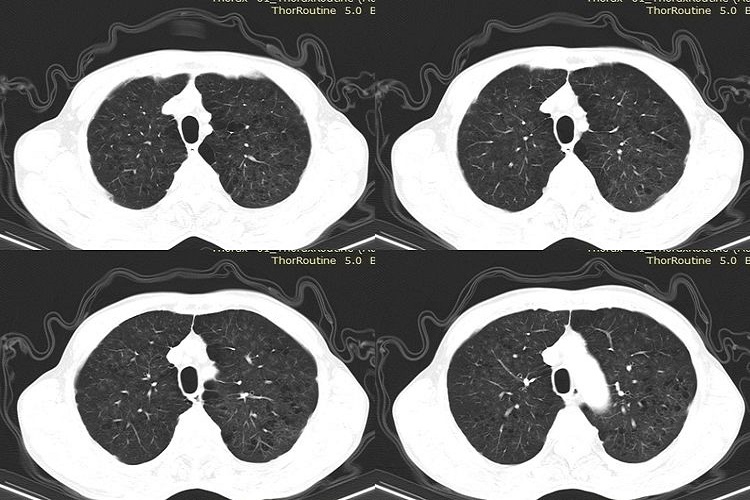
早期矽肺CT图

概述
早期矽肺CT表现为双肺多发、无融合的小结节影,大小不等,患者需要及时在医生指导下进行相应治疗。
CT表现
早期矽肺CT特征表现为双肺多发、无融合的小结节影,大小不等,多为2-5mm,位于小叶中心和胸膜下,可发生钙化。早期结节多位于上肺,但中、下肺也较常见,在CT上92.4%的病变分布于后肺野,肺内网状阴影不明显。
治疗措施
矽肺确诊之后,患者应脱离粉尘作业岗位,病情较重者应休息或安排疗养,在冬、春两季要注意防止呼吸道感染。患者应在医疗监护下工作或休息,做保健操和太极拳等活动,以增强体质。同时需要遵医嘱对症治疗,以缓解症状、减轻痛苦,药物治疗矽肺的基本原则是镇咳化痰、消炎平喘,常用药物为矽肺宁片、汉防己甲素片等。
参考文献
[1]黄宝生著.胸部CT鉴别诊断学[M].兰州.甘肃科学技术出版社.2016.111.
[2]理查德·韦伯著.2017高分辨率肺部CT全新第5版[M].北京.中国科学技术出版社.2017.396.
展开
